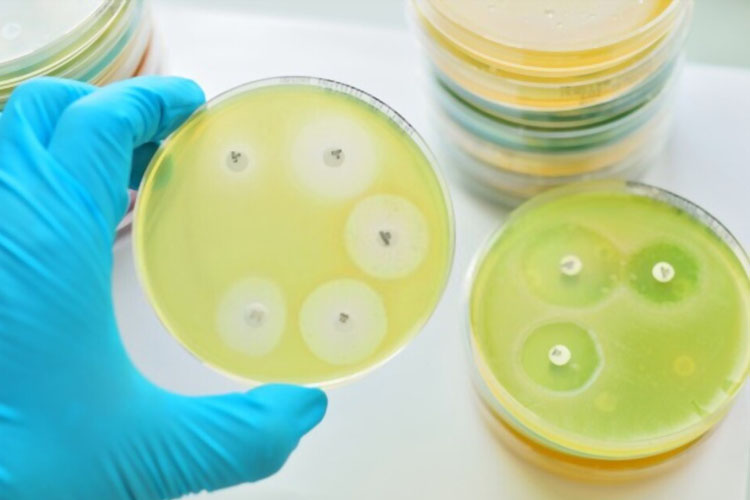

SilvoGuard® antimicrobial medical devices are made using the patented, Broad-spectrum antimicrobial solution – NanoAgCideTM with active silver nanoparticles in it
Once the medical device is inserted into a patient’s body, there is a sustained, slow release of active silver ions
These silver ions are adept to kill all sorts of bacteria that comes in close vicinity or in contact of the medical device, consequently preventing HAI
 +91 9867 468 149
+91 9867 468 149 info@silvoguard.com
info@silvoguard.com